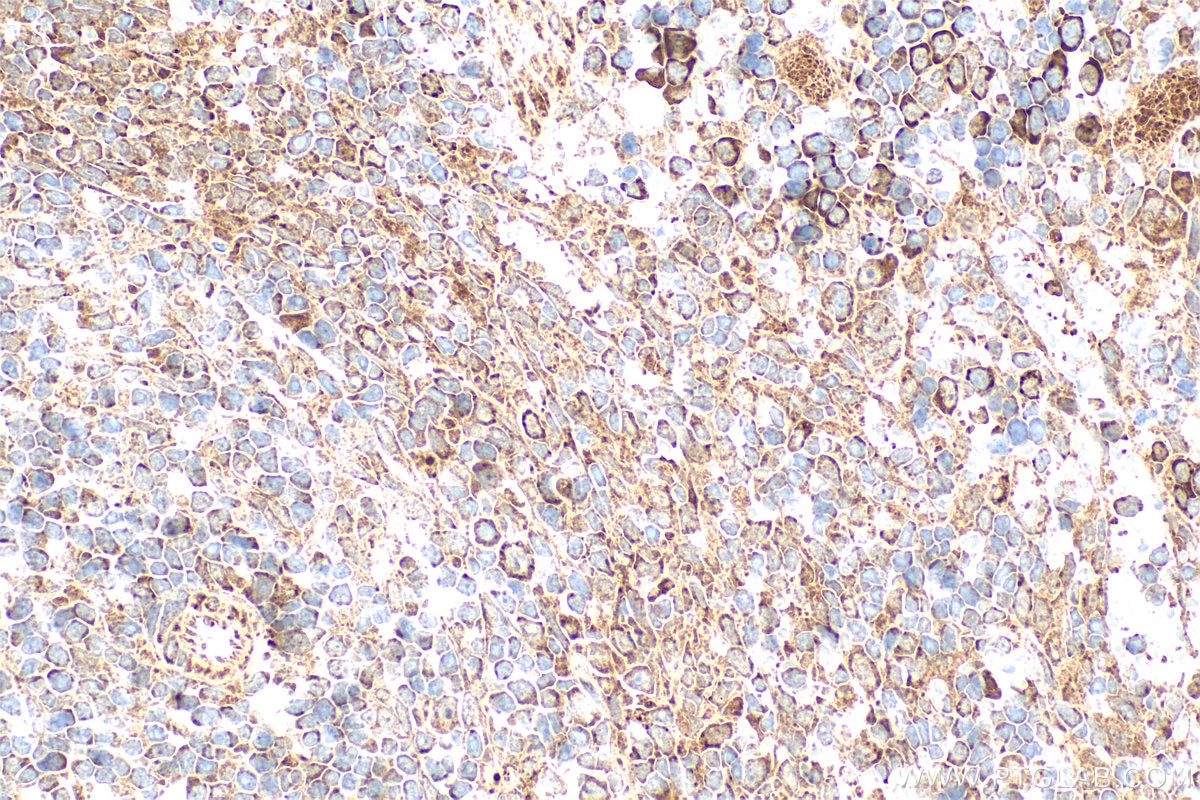
Immunohistochemistry (IHC) staining of rat spleen tissue using EPO/Erythropoietin Polyclonal antibody (17908-1-AP)

Validation Data Gallery
Tested Applications
| Positive WB detected in | HEK-293 cells |
| Positive IHC detected in | rat kidney tissue, mouse spleen tissue, rat spleen tissue Note: suggested antigen retrieval with TE buffer pH 9.0; (*) Alternatively, antigen retrieval may be performed with citrate buffer pH 6.0 |
Recommended dilution
| Application | Dilution |
|---|---|
| Western Blot (WB) | WB : 1:200-1:1000 |
| Immunohistochemistry (IHC) | IHC : 1:50-1:500 |
| It is recommended that this reagent should be titrated in each testing system to obtain optimal results. | |
| Sample-dependent, Check data in validation data gallery. | |
Published Applications
| WB | See 3 publications below |
| IHC | See 2 publications below |
Product Information
17908-1-AP targets EPO/Erythropoietin in WB, IHC, ELISA applications and shows reactivity with human, mouse, rat samples.
| Tested Reactivity | human, mouse, rat |
| Cited Reactivity | human, rat, canine |
| Host / Isotype | Rabbit / IgG |
| Class | Polyclonal |
| Type | Antibody |
| Immunogen |
CatNo: Ag12302 Product name: Recombinant human EPO protein Source: e coli.-derived, PGEX-4T Tag: GST Domain: 3-193 aa of BC093628 Sequence: VHECPAWLWLLLSLLSLPLGLPVLGAPPRLICDSRVLERYLLEAKEAENITTGCAEHCSLNENITVPDTKVNFYAWKRMEVGQQAVEVWQGLALLSEAVLRGQALLVNSSQPWEPLQLHVDKAVSGLRSLTTLLRALGAQKEAISPPDAASAAPLRTITADTFRKLFRVYSNFLRGKLKLYTGEACRTGDR 相同性解析による交差性が予測される生物種 |
| Full Name | erythropoietin |
| Calculated molecular weight | 193 aa, 21 kDa |
| Observed molecular weight | 37 kDa |
| GenBank accession number | BC093628 |
| Gene Symbol | EPO/Erythropoietin |
| Gene ID (NCBI) | 2056 |
| RRID | AB_10638147 |
| Conjugate | Unconjugated |
| Form | |
| Form | Liquid |
| Purification Method | Antigen affinity purification |
| UNIPROT ID | P01588 |
| Storage Buffer | PBS with 0.02% sodium azide and 50% glycerol{{ptg:BufferTemp}}7.3 |
| Storage Conditions | Store at -20°C. Stable for one year after shipment. Aliquoting is unnecessary for -20oC storage. |
Background Information
Erythropoietin (Epo) is a member of the EPO/TPO family and encodes a secreted, glycosylated cytokine composed of four alpha helical bundles. Erythropoietin (Epo) is a 166 amino acids protein containing three N-glycosylation sites (Asn-24, Asn-38, and Asn-83) and 1 O- glycosylation site (Ser-126) and involved in the regulation of the level of red blood cells. The protein is found in the plasma and regulates red cell production by promoting erythroid differentiation and initiating hemoglobin synthesis. Its effect is realized by binding erythropoietin receptor (EpoR) expressed on erythroid progenitor cells. EpoR, is a glycoprotein expressed on megakaryocytes, erythroid progenitors and endothelial cells. Epo also has neuroprotective activity against a variety of potential brain injuries and antiapoptotic functions in several tissue types.
Protocols
| Product Specific Protocols | |
|---|---|
| IHC protocol for EPO/Erythropoietin antibody 17908-1-AP | Download protocol |
| WB protocol for EPO/Erythropoietin antibody 17908-1-AP | Download protocol |
| Standard Protocols | |
|---|---|
| Click here to view our Standard Protocols |
Publications
| Species | Application | Title |
|---|---|---|
Front Genet Identification and Validation of a Tumor Microenvironment-Related Gene Signature in Hepatocellular Carcinoma Prognosis. | ||
Front Pharmacol Dimethyloxalylglycine pretreatment of living donor alleviates both donor and graft liver ischemia-reperfusion injury in rats | ||
Front Mol Neurosci The cytokine receptor CRLF3 is a human neuroprotective EV-3 (Epo) receptor | ||
Int J Clin Oncol The miR-199a-5p/HIF1α dual-regulatory axis participates in hypoxia-induced aggressive phenotypes of oral squamous cell carcinoma (OSCC) cells |